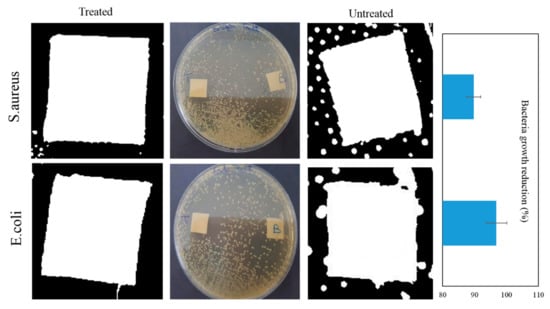

Abstract
The purpose of this work was to prepare chitosan–essential oil microcapsules using the simple coacervation method and to graft them onto cellulosic fibers to obtain bio functional textile. The microcapsules morphology was characterized by optical microscopy. The 2D dimethyloldihydroxyethylene urea resin (DMDHEU) was used as a binding agent to graft microcapsules on the surface of cellulosic fibers. Scanning Electron Microscopy (SEM) photographs and Attenuated Total Reflectance-Fourier Transformed Infrared (ATR-FTIR) analyses were performed to prove the interaction between cellulosic fibers and microcapsules. Furthermore, the properties of the different fabrics such as mechanical strength and air permeability were investigated. Furthermore, washing durability was evaluated. Finally, the antibacterial activity of the finished fibers against the strains Escherichia coli (E. coli) and Staphylococcus aureus (S. aureus) was evaluated. The results evidence the ability of treated fabrics to induce bacteria growth inhibition. The coacervation method is a simple process to incorporate cinnamon essential oil on the cellulosic fiber’s surface. The use of essential oils as active agents seems to be a promising tool for many protective textile substrates such as antimicrobial masks, bacteriostatic fabrics and healthcare textiles.
1. Introduction
In recent years, the incidence of viruses, bacteria, parasites and fungi has risen considerably, especially among immune-compromised patients, geriatric and pediatric [1]. The uncontrolled growth of infectious diseases, which are becoming harder to treat, is a silent threat with long-term consequences for global public health and economy [2]. The COVID-19 crisis has brought into sharp focus the impact of infectious diseases. There are vital lessons to learn from this pandemic. Now more than ever, we need to make robust and comprehensive investments into the way we prepare and respond to health emergencies. This has the potential to avoid into long-term, global health threats and economic crises. A major challenge facing textile industries is to enhance the production of protective textiles. Natural fibers such as cotton are sensitive to microorganisms attack since their structure is hydrophilic and porous, allowing the retention of oxygen, moisture and nutrients required for microorganism development.
The healthcare sector consumes large amounts of textiles such as staff uniforms, patient clothing, operation room gowns and bed linen. Placing advanced properties and green criteria during production can increase the demand for antimicrobial finishing preventing microorganisms from adhering to the textile surface.
During the last decade, a number of antimicrobial textiles have been developed using techniques like the incorporation of antimicrobial agents into the synthetic fibers during extrusion, the surface grafting of active compounds or the fiber modification by physical or chemical treatments [3].
Several antimicrobial agents were imparted to textiles like triclosan, quaternary ammonium compounds, metal salts, polybiguanides and N-halamines [4].
However, the main disadvantage remains that these active components present drawbacks such as leaching of textiles during washing causing environmental problems and toxicity when exposed to sunlight such as for Triclosan, an efficient antimicrobial agent that has been banned by many countries [4].
Textile antimicrobial finishing needs to be effective against microorganisms, but the more important issue is the increasing demand of non-toxicity to the environment and the user [5]. Therefore, medical textile industries need to use new active agents that are safe and which present a broad spectrum of activity to ensure the control of microbes’ multiplicity. In addition, optimum efficiency must be reached while providing the properties of textiles.
Recently, essential oils have been emerging as effective antimicrobial agents [6]. They are highly concentrated substances extracted from plant organs such as flowers, leaves, bark and seeds [7].
They contain various aromatic compounds [8]. These natural products have the advantage of providing a broad spectrum of biological activities [9]. This property makes them promising active agents to fight against the spread of multi-resistant microorganisms, which is one of the greatest challenges medical textile industries need to face.
Despite their antimicrobial activity, essential oils are not widely exploited in the textile sector since they do not dissolve in water [10]. To overcome this problem, Chitosan could be used to encapsulate these active compounds [11]. The target of the present work is to achieve cinnamon oil encapsulation using Chitosan and to graft the obtained microcapsules onto the cellulosic fiber’s surface. The physio-chemical characteristics and antibacterial activity of finished samples were investigated.
2. Materials and Methods
2.1. Materials
Woven cotton fabric (areal mass density 280 g/m2, threads per cm: warp 48 ± 2; weft 37 ± 1, and CIE whiteness 80) was purchased from the local market. The fabric was desized, bleached and mercerized.
Chitosan (deacetylation degree of 70%), acetic acid and NaOH were purchased from Sigma Aldrich. Tween 20 (surfactant) and dimethyloldihydroxyethylene urea DMDHEU (binding agent) were donated by Chimitex Plus company (Sousse, Tunisia). Barks of Ceylon cinnamon were obtained from shops. This species is not planted in Tunisia. However, the material is easy to obtain since cinnamon is commonly used as a spice in Tunisian cooking.
2.2. Methods
2.2.1. Essential Oil Extraction
The hydro-distillation was carried out for 3 h: 30 min, according to the following experimental protocol. An Amount of 250 g of mashed cinnamon sticks was laid out in a distillation flask containing water, then the system was brought to the boil. A condenser was placed between the distillation flask and the receiving container. The vapor produced in the flask drains the volatile components and then passes to the condenser, where it is condensed. After condensation, the volatile compounds are collected, cooled at room temperature and separated using a separatory funnel. The oil is recovered after decantation.
2.2.2. Microcapsules Preparation
Chitosan-essential oil microcapsules were prepared using the simple coacervation method [12]. Cinnamon essential oil (16 mL) was mixed with tween 20 (0.1 mL) and 1% Chitosan solution (50 mL) in 1% acetic acid (pH = 4). The solution was emulsified using an Ultra-Turrax (IKA, Staufen, Germany) operating at a speed of 900 rpm. The obtained emulsion was then slowly added to 250 mL of NaOH (0.2 M)/ethanol (4/1). The mixture was gently stirred to induce microcapsules formation and reinforcement of their walls.
2.2.3. Grafting of Microcapsules onto Fabric Surface
The cotton samples were submerged in the finishing bath, which contains the microcapsules emulsion (80 g/L) and the binding agent (40 g/L). The samples were then padded to obtain a wet pick up of 80%, pre-dried at 90 °C for 15 min, cured at 150 °C for 5 min, and stored at room temperature.
2.3. Characterization and Measurements
2.3.1. Optical Microscopy
The aspects of the microcapsules solution and the treated fibers were observed using an optical microscope (Leica DM 500, Leica Microsystems, Heerbrugg, Switzerland) connected to a Colorview camera and controlled by analysis software. The microscope is equipped with different objectives, allowing imaging with different magnifications. A slide and a cover glass were used to place a droplet of the solution or a treated fiber between them in order to observe under microscope. Photographs were taken in transmission mode under ×100 magnification.
2.3.2. Scanning Electron Microscopy
The untreated and treated cotton fabrics were characterized by a scanning electron microscope (JEOL JSM5400, JEOL Ltd., Tokyo, Japan). Sputter coating of the samples with conductive gold was achieved and imaging parameters were adjusted to obtain high quality images and to protect the original state of cotton fabrics.
2.3.3. ATR-FTIR Spectroscopy
An attenuated Total Reflectance-Fourier Transformed Infrared (ATR-FTIR, Perkin Elmer, Waltham, MA, USA) was used to examine the chemical changes of chitosan after essential oil loading and fabric surface after microcapsules grafting. The spectra were obtained via Spectrum Two™ FTIR (Perkin Elmer) and recorded with a spectral resolution of 4 cm−1 in the range 4000–400 cm−1.
2.3.4. Encapsulation Efficiency and In Vitro Release of Essential Oil
The encapsulation efficiency of essential oil was evaluated using a UV/VIS spectrophotometer (Specord 210 plus, Analytik Jena AG, Jena, Germany). To determine residual oil, the microcapsules solution (1 mL) was mixed with hexane (9 mL). The mixture was allowed to settle for 10 min. The extracted residual oil in hexane was determined using spectrophotometer at 285 nm. The encapsulation efficiency (%) was calculated using a calibration curve constructed from the values of different concentrations of the cinnamon essential oil. The wavelength of 285 nm was considered for all the measurements. This value corresponds to the characteristic wavelength of cinnamaldheyde the main component of cinnamon oil.
The UV-Visible spectrum of cinnamon essential oil is shown in Figure 1. The Encapsulation efficiency (percentage) was then obtained as a percentage from the following equation:

Figure 1.
UV-visible spectra of cinnamon essential oil.
To determine the essential oil release, samples of 1 g of the finished fabric were submerged in hexane under agitation for 1 h at ambient temperature. The amount of oil released into the bath was quantified by UV/Vis Spectrophotometer at 285 nm. The Beer-Lambert law was used to measure the concentration of released oil based on the calibration curve of cinnamon oil.
2.3.5. Mechanical Properties
Mechanical tests were conducted according to NF EN ISO 13934-2 standards (in warp direction) via a testing machine (Lloyd LR 5 k, Lloyd Instruments Ltd., Largo, FL, USA). The load cell was 5 kN and the extension speed was 50 mm/min. Test samples had a gauge length of 75 mm and a thickness of 1 mm. Tests were run in triplicate.
2.3.6. Air Permeability
Air permeability of the specimens was determined according to the standard method ISO 9237 via an air permeability tester FX 3300 (Karl Schröder KG, Weinheim, Germany) at a constant pressure drop of 200 Pa.
2.3.7. Laundering Durability
Laundering durability was evaluated via a standard domestic washing process performed at 40 °C for 30 min using a detergent (anionic). After the washing process, samples were rinsed with water and dried at ambient temperature. To quantitatively evaluate the microcapsules attachment durability, microcapsules were counted on fibers surface using the optical microscope. A lot of fibers were separated from the treated fabric, the treated fabric after 5 washing cycles and the treated fabric after 10 washing cycles. The mean number and the standard deviation (SD) were calculated.
2.4. Antibacterial Activity
Antibacterial activity of treated fabrics was studied using the diffusion assay method. The tests were realized using the strains Escherichia coli (ATCC 8739), chosen because 80% of all infections are caused by gram-negative bacteria [13], and Staphylococcus aureus (ATCC 25923), used as a representative strain of gram-positive bacteria [14].
Prior to performing the experiments, all cotton samples were sterilized in the following conditions: Temperature 120 °C, pressure 100 kPa and time 20 min. The autoclaving process is fast and does not result in a loss of encapsulated essential oil. The microcapsules are able to protect the oil from volatilisation [15,16].
The microorganisms were cultured in petri dishes containing a nutrient agar and were incubated at 37 °C for 24 h. To adjust cell density to 108 colony forming units per milliliter (CFU/mL), the cultured microorganisms were diluted using a sterile saline physiologic solution. The optical density of the diluted suspension was considered to estimate the cell density. A total of 100 μL of the diluted suspension was spread with a sterile cotton swab on the surface of the nutrient agar contained in the petri dish. Then, the cotton samples (1 × 1 cm2) were placed into a cultured nutrient agar petri dish and slightly pressed on the surface (transversely). The petri dishes with the cotton samples were incubated for 24 h at 37 °C. It is important to mention that the samples were lightly rubbed before the test.
Tests were conducted in duplicate. Images showing bacteria growth in the presence of cotton fabrics were saved and then treated with the software ImageJ. This software allows having quantifiable data from images. The number of pixels of the area covered with bacteria (near the edges of the fabric) is calculated and compared to that of the total uncovered area (the total area excluding the sample area). Therefore, the percentage of the area covered with bacteria is calculated.
3. Results and Discussion
3.1. Morphological Structure
The morphology of Chitosan-cinnamon oil microcapsules was investigated based on their optical micrograph. (Figure 2a). Optical micrograph shows that most of the microcapsules are spherical with no visible aggregation in them. The observed microcapsules present non-uniform size (the diameter varied between 20–50 μm) with clear differentiation between wall and core material. In previous studies, it has been reported that the non-uniformity of size results from a partial agglomeration of oil suspension before encapsulation [11].

Figure 2.
Optical photographs of (a) microcapsules solution (b) microcapsule on the cellulosic fiber surface and (c) a number of microcapsules throughout the length of the cellulosic fiber.
Optical microscopy was also used to observe the cellulosic fibers after treatment. As shown in Figure 2b,c micrographs of the treated cotton fibers confirmed that microcapsules have been successfully deposited on their surface. The microcapsules have conserved their spherical shape (Figure 2b) and their distribution was observed throughout the length of the fiber (Figure 2c).
The morphology of the treated sample was studied by SEM. Figure 3 shows the known spiral structure of cotton fiber. The fiber’s surface appears relatively smooth with the presence of spherical entities, which are the microcapsules.

Figure 3.
SEM images of treated fabric: (a) under ×200 magnification and (b) under ×400 magnification.
The treatment does not appear to damage the state of the fibers as evidenced by the SEM images. The fibers do not show any deterioration or degradation aspects in fibers.
3.2. ATR-FTIR Results
The solution of Chitosan microcapsules loaded with essential oil was analyzed by ATR FTIR. The spectrum (Figure 4) shows changes compared to the spectrum of pure Chitosan such as the fusion of the peak at 1650 cm−1 (amide I) with the peak at 1550 cm−1 (amide II). The two peaks appear with a wide absorption at 1640 cm−1. In addition, the spectrum of microcapsules solution shows a characteristic large band around 3329 cm−1. This band reveals the presence of OH groups (microcapsules aqueous solution).

Figure 4.
ATR-FTIR spectra of pure chitosan and chitosan loaded with essential oil.
The FTIR-ATR spectra of control fabric and treated fabric are shown in Figure 5. As expected, the FTIR spectra show characteristic peaks of cellulose. The stretching vibration of the hydroxyl group gives a broad peak at 3339 cm−1. The band at 2897 cm−1 is characteristic of CH stretching vibration. Typical bands observed in the region of 1630–900 cm−1 are assigned to cellulose. The stretching and bending vibrations of –CH2 and –CH, –OH and C–O bonds in cellulose gives the bands at 1428, 1368, 1317, 1061 cm−1 and 895 cm−1. The bands at 895 cm−1 and around 1420–1430 cm−1 are associated to the amorphous and crystalline structure of the cellulose, respectively [17].

Figure 5.
ATR-FTIR spectra of the treated, DMDHEU treated and untreated cotton fabrics.
The ATR-FTIR spectrum of DMDHEU treated cotton (without microcapsules) shows additional absorption peaks at 1746 and 1642 cm−1. These peaks correspond to the C=O bond of ester groups resulting from crosslinking reaction (Figure 6) [18,19].

Figure 6.
Chemical reaction between DMDHEU resin and Cotton/Microcapsules.
The peak around 3200–3400 cm−1 was broadened after the grafting of microcapsules. This funding is probably due to the overlapping of hydroxyl groups with the N-H vibration from Chitosan structure. Furthermore, the intensity of bands at 1690, 1570 and 1428 cm−1 was increased. These peaks belonged to the functional groups of amide I and amide II originated from the Chitosan [20]. This finding is in agreement with SEM results and confirmed the successful attachment of Chitosan-cinnamon oil microcapsules.
3.3. Encapsulation Efficiency and In Vitro Release of Essential Oil
The essential oil loading efficiency is an important detail for cotton functionalization purposes using microcapsules. It gives an idea of the amount of active component entrapped into them. The microcapsules loading efficiency was found to be 78.95 ± 3.64%. This funding is in agreement with previous results in studies dealing with chitosan-essential oil microcapsules preparation [21,22].
The essential oil release presents the fraction of cinnamon oil incorporated into cotton fabric grafted with microcapsules. The release of the essential oil was found to be 6.16 ± 0.71 µL/g, which was close to the values reported in the literature [16].
3.4. Mechanical Properties
Figure 7 shows the load–extension curves of the control and treated cotton fabrics. Both fabrics show a brittle failure with a sudden load drop when reaching a maximum load.

Figure 7.
Tensile strength test: (a) Cotton sample dimensions, (b) The Apparatus for tensile test and (c) Load-extension curves of control and treated cotton fabrics.
As presented in Figure 7, the untreated sample showed the lower maximum breaking strength. After the microcapsules grafting, the value of maximum breaking strength increased. This result could be explained by the change of the surface topography. The roughening effect creates additional contact points within the fibers, resulting in enhanced interfiber friction. The low friction induces a weak cohesion between fibers and yarns [23].
Elongation provides an indication of the stretch rate of the fabric. Treated fabric was found to exhibit a reduced elongation rate; this behavior is due to less mobility of yarns and fibers and within the fabric. The binding agent, used for enhancing microcapsules attachment, results in an increase in the interaction force between yarns and fibers, leading to the reduction in their movement during extension.
3.5. Air Permeability
Air permeability is an important property for the final use of the treated textile. It provides an idea of the breathability of fabrics. Figure 8 shows that air permeability had slightly decreased after treatment. During the grafting process, yarn hair is generated and the space between the yarns is reduced. Fabric porosity is affected, resulting in low air permeability [24].

Figure 8.
Air permeability of cotton fabrics.
3.6. Laundering Durability
Durability of microcapsules adhesion after the washing process is an interesting detail for farther functional application of treated fabrics.
Washing resistance is a big concern for the textile finishing industry, so it is necessary to control the washing durability of finished fabrics. Results in the literature showed that fabrics grafted with microcapsules exhibit a washing resistance after 5 to 40 times [16].
Figure 9 shows that an important number of microcapsules was still remaining on the fibers after five washing cycles. However, a decrease in the number of fixed microcapsules was noticed after ten washing cycles.

Figure 9.
Optical photographs of treated fabric after washing cycles.
The mean number was considered to determine the washing durability of the treatment. Table 1 presents the results of microcapsules counting for different treated fabrics. The average number is 7.2 for the treated fabric before wash, 5 after five cycles and 0.9 after ten cycles.

Table 1.
Microcapsules number before and after washing cycles.
The content of microcapsules on the fibers has gradually decreased as the number of washing cycles increased. The washing resistance of the treated fabrics after five washing cycles was due to the penetration of microcapsules into the voids between the fibers. In addition, the Chitosan, forming the microcapsules walls, is sticky by nature. This property makes the microcapsules resistant to wash.
Furthermore, the use of DMDHEU during the finishing process enhances the microcapsules’ attachment to the surface of the fibers. Strong chemical bonds are formed. These bonds prevent the microcapsules from falling during the washing stage.
3.7. Antibacterial Activity
Figure 10 shows the qualitative and quantitative results of antibacterial activity. Untreated cotton did not show an inhibiting effect of bacteria. The bacterial growth was expanded around the samples. However, a peripheral inhibition was observed at the edges of treated samples. The microcapsules grafting on cotton fibers has led to a reduction in the bacteria growth of around 90% for the strain S. aureus and around 97% for the strain E. coli.
Figure 10.
Antibacterial activity results of treated and untreated fabrics.
The treated fabrics were able to inhibit the growth of the tested strains. According to previous reports, the resulting antibacterial activity is mainly due to the cinnamaldehyde, the major compound of cinnamon oil [25] after the oil release through the microcapsules wall and not from the Chitosan itself.
4. Conclusions
During this study, cinnamon oil was encapsulated using the coacervation technique and immobilized on the cotton fabrics.
Various characterization methods have allowed the evaluation of the microcapsules morphology and the efficiency of their grafting on the cellulosic fibers. Furthermore, mechanical properties and air permeability of different samples were tested. Washing durability was also evaluated. Finally, the resistance of treated fabric to bacteria growth was assessed using a qualitative method on gram-positive and gram-negative bacteria strains. Cotton grafting with chitosan-essential oil microcapsules was found to be a promising finishing process for the development of bio functional textile materials. Besides, essential oil appears as an interesting safe antibacterial agent.
Author Contributions
Conceptualization, A.B. (Aicha Bouaziz), D.D. and S.G.; methodology, A.B. (Aicha Bouaziz), D.D. and S.G.; experiments, A.B. (Aicha Bouaziz), D.D., S.G. and A.Z.; validation, H.M., C.B. and A.B. (Aghleb Bartegi); analysis, A.B. (Aicha Bouaziz), D.D., S.G., A.Z. and H.M.; investigation, A.B. (Aicha Bouaziz), D.D. and S.G.; resources, C.B. and H.M.; writing original draft preparation, A.B. (Aicha Bouaziz), D.D., S.G. and H.M.; writing review and editing A.B. (Aicha Bouaziz), D.D., S.G. and H.M.; supervision, A.B. (Aghleb Bartegi), H.M. and C.B.; project administration, S.G. and C.B. All authors have read and agreed to the published version of the manuscript.
Funding
This research received no external funding.
Institutional Review Board Statement
Not applicable.
Informed Consent Statement
Not applicable.
Data Availability Statement
Data sharing is not applicable to this article.
Conflicts of Interest
The authors declare no conflict of interest.
References
- Lee, P.P.; Lau, Y.-L. Cellular and molecular defects underlying invasive fungal infections—revelations from endemic mycoses. Front. Immunol. 2017, 8, 735. [Google Scholar] [CrossRef] [PubMed]
- Prestinaci, F.; Pezzotti, P.; Pantosti, A. Antimicrobial resistance: A global multifaceted phenomenon. Pathog. Glob. Health 2015, 109, 309–318. [Google Scholar] [CrossRef] [PubMed]
- Morais, D.S.; Guedes, R.M.; Lopes, M.A. Antimicrobial approaches for textiles: From research to market. Materials 2016, 9, 498. [Google Scholar] [CrossRef] [PubMed]
- Shabbir, M.; Yusuf, M.; Mohammad, F. Insights into Functional Finishing Agents for Textile Applications. In Hanbook of Textile Coloration and Finishing: Studium Press; USA LLC: New York, NY, USA, 2017; pp. 97–115. [Google Scholar]
- Joshi, M.; Purwar, R.; Ali, S.W.; Rajendran, S. Antimicrobial textiles for health and hygiene applications based on eco-friendly natural products. Med. Healthc. Text. 2010, 84–92. [Google Scholar] [CrossRef]
- Mittal, R.P.; Rana, A.; Jaitak, V. Essential oils: An impending substitute of synthetic antimicrobial agents to overcome antimicrobial resistance. Curr. Drug Targets 2019, 20, 605–624. [Google Scholar] [CrossRef]
- Tongnuanchan, P.; Benjakul, S. Essential oils: Extraction, bioactivities, and their uses for food preservation. J. Food Sci. 2014, 79, R1231–R1249. [Google Scholar] [CrossRef]
- Tassoul, M.; Shaver, R. Effect of a mixture of supplemental dietary plant essential oils on performance of periparturient and early lactation dairy cows. J. Dairy Sci. 2009, 92, 1734–1740. [Google Scholar] [CrossRef]
- Ali, B.; Al-Wabel, N.A.; Shams, S.; Ahamad, A.; Khan, S.A.; Anwar, F. Essential oils used in aromatherapy: A systemic review. Asian Pac. J. Trop. Biomed. 2015, 5, 601–611. [Google Scholar] [CrossRef]
- de Souza, H.J.B.; Dessimoni, A.L.d.A.; Ferreira, M.L.A.; Botrel, D.A.; Borges, S.V.; Viana, L.C.; Oliveira, C.R.d.; Lago, A.M.T.; Fernandes, R.V.d.B. Microparticles obtained by spray-drying technique containing ginger essential oil with the addition of cellulose nanofibrils extracted from the ginger vegetable fiber. Dry. Technol. 2020, 1–15. [Google Scholar] [CrossRef]
- Javid, A.; Raza, Z.A.; Hussain, T.; Rehman, A. Chitosan microencapsulation of various essential oils to enhance the functional properties of cotton fabric. J. Microencapsul. 2014, 31, 461–468. [Google Scholar] [CrossRef]
- Bustos, R.; Romo, L.; Yáñez, K.; Díaz, G.; Romo, C. Oxidative stability of carotenoid pigments and polyunsaturated fatty acids in microparticulate diets containing krill oil for nutrition of marine fish larvae. J. Food Eng. 2003, 56, 289–293. [Google Scholar] [CrossRef]
- Savaloni, H.; Haydari-Nasab, F.; Abbas-Rohollahi, A. Antibacterial effect, structural characterization, and some applications of silver chiral nano-flower sculptured thin films. J. Theor. Appl. Phys. 2015, 9, 193–200. [Google Scholar] [CrossRef]
- Davis, C.; Wagle, N.; Anderson, M.; Warren, M. Bacterial and fungal killing by iontophoresis with long-lived electrodes. Antimicrob. Agents Chemother. 1991, 35, 2131–2134. [Google Scholar] [CrossRef]
- Hsieh, W.-C.; Chang, C.-P.; Gao, Y.-L. Controlled release properties of chitosan encapsulated volatile citronella oil microcapsules by thermal treatments. Colloids Surf. B Biointerfaces 2006, 53, 209–214. [Google Scholar] [CrossRef]
- Zhang, T.; Luo, Y.; Wang, M.; Chen, F.; Liu, J.; Meng, K.; Zhao, H. Double-layered microcapsules significantly improve the long-term effectiveness of essential oil. Polymers 2020, 12, 1651. [Google Scholar] [CrossRef]
- Hospodarova, V.; Singovszka, E.; Stevulova, N. Characterization of cellulosic fibers by FTIR spectroscopy for their further implementation to building materials. Am. J. Anal. Chem. 2018, 9, 303–310. [Google Scholar] [CrossRef]
- Kongdee, A.; Bechtold, T. Cellulose-Protein Textiles: Utilisation of Sericin in Textile Finishing. In Ecotextiles; Elsevier: Amsterdam, The Netherlands, 2007; pp. 216–221. [Google Scholar]
- İlleez, A.A.; Dalbaşι, E.S.; Özçelik Kayseri, G. Seam Properties and Sewability of Crease Resistant Shirt Fabrics. AATCC J. Res. 2017, 4, 28–34. [Google Scholar] [CrossRef]
- Haque, A.N.M.A.; Remadevi, R.; Wang, X.; Naebe, M. Adsorption of anionic Acid Blue 25 on chitosan-modified cotton gin trash film. Cellulose 2020, 27, 9437–9456. [Google Scholar] [CrossRef]
- Wijesirigunawardana, P.B.; Perera, B.G.K. Development of a cotton smart textile with medicinal properties using lime oil microcapsules. Acta Chim. Slov. 2018, 65, 150–159. [Google Scholar] [CrossRef]
- Hussain, M.R.; Iman, M.; Maji, T.K. Determination of degree of deacetylation of chitosan and their effect on the release behavior of essential oil from chitosan and chitosan-gelatin complex microcapsules. Int. J. Adv. Eng. Appl. 2013, 6, 4–12. [Google Scholar]
- Lam, Y.L.; Kan, C.W.; Yuen, C.W.; Au, C.H. Objective measurement of fabric properties of the plasma-treated cotton fabrics subjected to cocatalyzed wrinkle-resistant finishing. J. Appl. Polym. Sci. 2011, 119, 2875–2884. [Google Scholar] [CrossRef]
- Du, W.; Zuo, D.; Gan, H.; Yi, C. Comparative study on the effects of laser bleaching and conventional bleaching on the physical properties of indigo kapok/cotton denim fabrics. Appl. Sci. 2019, 9, 4662. [Google Scholar] [CrossRef]
- El Atki, Y.; Aouam, I.; El Kamari, F.; Taroq, A.; Nayme, K.; Timinouni, M.; Lyoussi, B.; Abdellaoui, A. Antibacterial activity of cinnamon essential oils and their synergistic potential with antibiotics. J. Adv. Pharm. Technol. Res. 2019, 10, 63. [Google Scholar] [CrossRef]
Publisher’s Note: MDPI stays neutral with regard to jurisdictional claims in published maps and institutional affiliations. |
© 2021 by the authors. Licensee MDPI, Basel, Switzerland. This article is an open access article distributed under the terms and conditions of the Creative Commons Attribution (CC BY) license (https://creativecommons.org/licenses/by/4.0/).